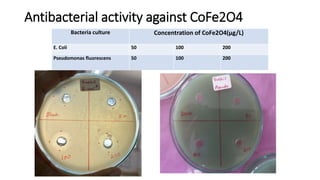
Antibacterial activity against CoFe2O4
Bacteria culture Concentration of CoFe2O4(µg/L)
E. Coli 50 100 200
Pseudomonas fluorescens 50 100 200

The document details the synthesis of cobalt ferrite (CoFe2O4) using a solid-state reaction method, emphasizing its environmental friendliness and characterization. It discusses the advantages of this method, its suitability for synthesizing nano ferrites, and explores the antibacterial activity of CoFe2O4 against various bacteria. Despite the cobalt ferrite's promising properties for electronic and magnetic applications, the study notes limited antibacterial effectiveness, warranting further research for clinical applications.